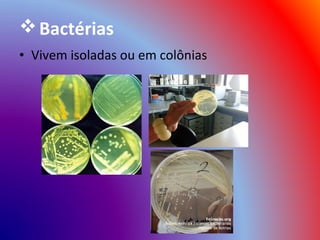
 Bactérias
• Vivem isoladas ou em colônias

Incorporar apresentação












O documento fornece informações sobre o Reino Monera. Resume que este reino contém organismos unicelulares procariontes, incluindo arqueobactérias, eubactérias e cianobactérias. Detalha aspectos como estrutura celular, formas de vida, características como fotossíntese ou heterotrofia, e tipos de respiração aeróbica ou anaeróbica. Também lista bactérias benéficas e doenças causadas por bactérias.